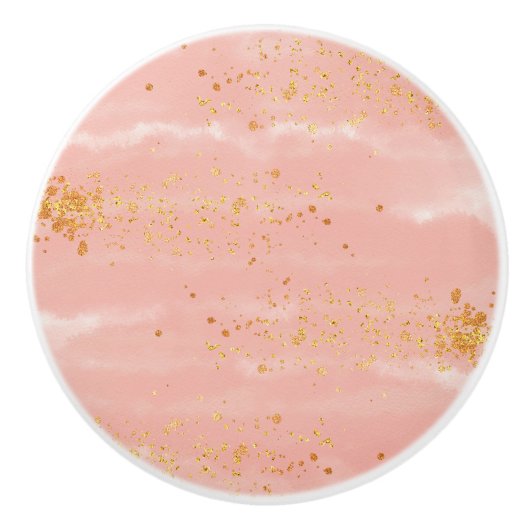
Rosie Drama Keramikknauf (Vorderseite)

Über Keramikgriffe
Verkauft von
Über dieses Design
Rosie Drama Keramikknauf
Rosie Zeichnete Pull. Die zauberhaften Mischungen aus Rose und Gold machen diesen Zug einfach reizbar.
Automatische Übersetzung
Kundenrezensionen
5.0 von 5 Sternen Bewertung1 Bewertungen insgesamt
1 Bewertungen
Bewertungen für ähnliche Produkte
5.0 von 5 Sternen Bewertung
5 von 5 Sternen BewertungVon Burkhard E.13. Dezember 2019 • Geprüfter Kauf
Bewertungsprogramm bei Zazzle
Die erworbenen Keramikknöpfe sind personifiziert und damit etwas besonderes. Meine Familie heißt Erdmann und dadurch bekommt das Wappen auf den Knöpfen eine besondere Bedeutung. Die Verarbeitung ist wirklich super. Ich hätte nie gedacht, dass die Oberfläche so glatt ist. Einfach nur toll. Mega Detailgetreu. Alles super scharf zu sehen und das trotz der kleinen "Größe".
Tags
Andere Informationen
Produkt ID: 256052772017159020
Gemacht am: 1.2.2020, 4:13
Bewertung: G